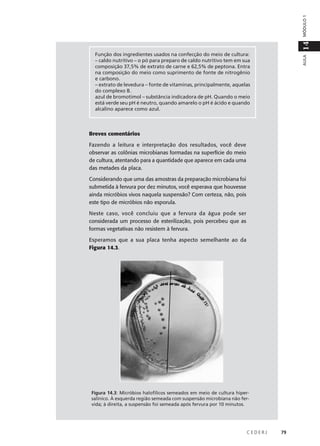
C E D E R J 79
AULA
14MÓDULO1
Função dos ingredientes usados na confecção do meio de cultura:
– caldo nutritivo – o pó para preparo de caldo nutritivo tem em sua
composição 37,5% de extrato de carne e 62,5% de peptona. Entra
na composição do meio como suprimento de fonte de nitrogênio
e carbono.
– extrato de levedura – fonte de vitaminas, principalmente, aquelas
do complexo B.
azul de bromotimol – substância indicadora de pH. Quando o meio
está verde seu pH é neutro, quando amarelo o pH é ácido e quando
alcalino aparece como azul.
Breves comentários
Fazendo a leitura e interpretação dos resultados, você deve
observar as colônias microbianas formadas na superfície do meio
de cultura, atentando para a quantidade que aparece em cada uma
das metades da placa.
Considerando que uma das amostras da preparação microbiana foi
submetida à fervura por dez minutos, você esperava que houvesse
ainda micróbios vivos naquela suspensão? Com certeza, não, pois
este tipo de micróbios não esporula.
Neste caso, você concluiu que a fervura da água pode ser
considerada um processo de esterilização, pois percebeu que as
formas vegetativas não resistem à fervura.
Esperamos que a sua placa tenha aspecto semelhante ao da
Figura 14.3.
Figura 14.3: Micróbios halofílicos semeados em meio de cultura hiper-
salínico. À esquerda região semeada com suspensão microbiana não fer-
vida; à direita, a suspensão foi semeada após fervura por 10 minutos.

Este documento descreve uma aula prática sobre micróbios primitivos que vivem em ambientes hipersalínicos. O objetivo é mostrar a existência de arqueas halofílicas nesses ambientes e demonstrar o efeito do calor e de agentes químicos sobre esses micróbios. Os alunos irão cultivar micróbios halofílicos e testar o impacto de desinfetantes nessas culturas.